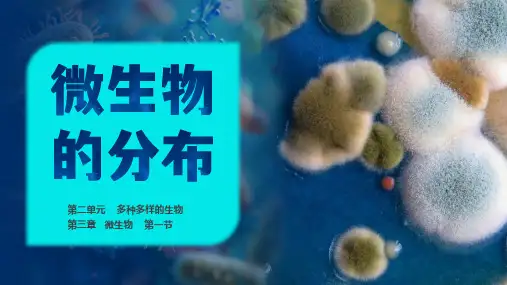

微生物分布种类及关系
- 格式:pptx
- 大小:2.23 MB
- 文档页数:22

淡水和海水中微生物的分布
1、淡水水体中微生物分布状况
地面水中微生物的种类和数量较多,一般与其所处的环境条件有关。
清洁的湖泊、池塘和水库中微生物较少,有机质丰富的湖泊中,微生物也较多。
停滞的塘水、污染的江河水以及下水道的沟水中,微生物较多。
地下水因经过深厚的土层过滤,几乎大部分微生物被阻留在土壤中。
2、海水微生物的分布和种类
海水中的微生物除来源于河水、雨水及污水等环境中临时种类外,绝大多数是嗜盐菌,并耐高渗透压。
水体中微生物的数量主要与有机质含量有关。
微生物在海水中的垂直分布一般规律为:表层主要是好氧性异养菌,低层水体中,主要是厌氧腐生及硫酸还原菌,两层之间紫硫菌较多。
在0~10米深的海水中,菌数较少,藻类和原生动物占较大比例,10~50米的海水中,菌数逐渐增加,50米以下,菌数逐渐减少,200米以下,菌数更少,在海底沉积物上,存在大量的微生物。



微生物的生物地理分布及其在全球环境变化中的作用微生物是指体积很小,只能用显微镜观察到的生物群体,包括细菌,古菌和真菌等。
它们分布在全球范围内,包括陆地、海洋、河流和湖泊等不同的环境中。
微生物的数量和多样性,以及它们的分布和作用,对全球的生态系统和环境具有重要影响。
不同类型的微生物的分布微生物在不同的环境中有不同的种类和数量。
例如,在土壤中,细菌是最常见的微生物,数量很大,而古菌的数量相对较少。
在海洋中,最常见的是浮游细菌和浮游真菌,它们分解了许多悬浮在海洋中的有机物质。
深海生物的生存和繁衍也依赖于微生物,细菌和古菌等微生物可以利用化学反应生成热量和能量,为海底生态系统提供支撑。
微生物的地理分布很大程度上受到环境因素的影响。
例如,环境的湿度、温度和营养状况等因素会影响微生物的生存能力。
此外,人类活动也会对微生物的分布产生影响。
例如,建设污染源和化肥使用等人类活动会导致微生物的分布和数量发生改变。
微生物对环境的作用微生物在环境中发挥着多种重要的作用。
其中最重要的是分解有机物。
微生物是土壤生态系统中的关键组成部分,它们分解了落叶、死亡的植物和动物等有机物质,使它们能够被植物吸收,促进了生态系统的健康和物质循环。
微生物还参与了许多生命系统和环境过程,包括地质作用、化学循环和大气组成等,对维持生态平衡具有重要作用。
微生物在全球环境变化中的作用微生物在全球气候变化中扮演着重要角色。
它们可以释放甲烷和二氧化碳等气体,这些气体对全球气候具有重要影响。
地球上的古菌,特别是在极端的环境下生存的古菌,可以帮助科学家了解地球上的生命起源和演化历程。
此外,研究微生物的适应性和多样性,可以为人类创造更加健康的环境提供理论和技术支持。
结论在全球环境变化不断加剧的今天,微生物的生物地理分布以及对环境的作用已经引起了人们的广泛关注。
人类需要更加重视微生物的研究,在保护和利用地球生态系统上发挥更加积极的作用。
将人类与自然相和谐发展,也需要我们对微生物的认识更加深入和全面。

大气中微生物的种类与分布大气中的微生物是指存在于地球大气中,能够生存和繁殖的微生物群体。
它们对大气生态系统以及人类健康有重要影响。
然而,大气微生物的种类和分布因地域、季节和气候条件等因素而异。
本文旨在介绍大气中微生物的种类和分布,并探讨其生态学和环境意义。
一、大气中微生物的种类大气中微生物的种类繁多,涵盖细菌、真菌、病毒、古菌等多种生物类群。
其中,细菌是大气微生物中最常见的类型,占据了大气微生物总量的绝大部分。
下面分别介绍一些常见大气微生物的种类。
1. 大气中的细菌(1)Bacillus属:广泛存在于大气生态系统中的芽孢杆菌,可以在没有水分和营养的环境中存活数十年甚至数百年。
(2)Pseudomonas aeruginosa:这种常见的一株革兰氏阴性菌,在水和大气中都有发现。
(3)Staphylococcus aureus:一种革兰氏阳性球菌,可在土壤、水与空气中都有分布。
2. 大气中的真菌(1)Aspergillus属:一种广泛存在于大气环境中的分枝菌属,它们具有广泛的代谢功能和适应能力。
(2)Alternaria属:常见的孢子形成菌,广泛分布于空气、土壤和水中。
(3)Cladosporium属:一种常见的真菌属,广泛存在于大气中,并能够在室内和室外环境中繁殖。
3. 大气中的病毒(1)农业作物中的病毒:包括普通农作物如小麦、翻子瓜、白菜、西瓜、香蕉等作物。
(2)人类疾病中的病毒:包括绿脓杆菌、沙门菌、麻疹病毒、腮腺炎病毒等。
4. 大气中的古菌热古菌(Thermoplasma acidophilum)是大气中的一种古菌。
这种菌属于迪克森氏菌(Crenarchaeota),是一种厌氧生物,生长在高温和较低水分的环境中。
二、大气中微生物的分布大气微生物的分布与其生态学特性密切相关。
不同地区、季节、气候和大气层次的差异会影响微生物群侵略潜力、繁殖率、代谢活动和定居区域。
下面分别介绍一下大气微生物在不同环境下的分布情况。

微生物的生态分布与功能多样性的关系分析微生物是一种非常基础、普遍存在的生物,它们在地球上的生态过程中扮演着非常重要的角色。
微生物不仅分布范围广泛,而且在生态环节中拥有着极高的功能多样性。
本文将从微生物的分布和功能两个方面,来分析微生物的生态分布与功能多样性的关系。
微生物的生态分布微生物包括细菌、真菌、古菌、病毒等,它们分布在地球上各种环境中,如土壤、水、空气、动物肠道等等。
有的微生物可以生存于极端条件下,如高温、高压、酸碱等极端环境,甚至可以在太空等极端环境中生存。
微生物的生态分布与环境因素有着密切的关系。
不同的微生物可以适应不同的环境,如产生化学物质的微生物集群在海洋中会随着潮汐变化而迁徙,而一些嗜盐菌则可以在盐湖中生存。
加之微生物数量巨大,数量级在千亿以上,因此微生物在生态过程中具有不可或缺的地位。
微生物的功能多样性微生物在地球上的生态过程中除了广泛分布外,还有着极高的功能多样性。
微生物可以参与多种生态过程,如物质循环、生物转化等;也有很多微生物可以作为工具来解决环境问题,如全球气候问题、水污染等。
微生物的功能多样性也与环境因素密切相关。
环境中不同物质元素的存在会导致微生物的代谢方式发生变化。
一些微生物可以通过对某些金属离子的还原产生能量,一些微生物则可以将硝酸根合成氨来做为氮源等等。
这些都表明了微生物在环境中有着各种复杂的代谢途径,可以参与各种生态过程。
微生物的生态分布与功能多样性的关系微生物的生态分布与功能多样性之间存在密切关联,这种关联体现在以下三方面:1. 微生物的分布适应了生态过程的需要微生物在地球上广泛分布并具有极高的数量,这使其可以在生态过程中充分发挥作用。
同时,微生物的分布根据环境因素有着不同的适应性,这保证了微生物对于生态过程的稳定参与。
2. 环境影响微生物的功能变化微生物的功能多样性是根据环境因素有所变化的。
例如,不同金属离子对于微生物的代谢途径的影响是不同的,不同微生物对于这些金属离子存在着不同的敏感性。

微生物群落在环境中的分布及其对生态系统的影响随着科学技术的不断进步,人们对微生物的研究也越来越深入。
微生物群落是由一群微生物共同组成的生态系统,被广泛应用于医学、环保和生态学等领域。
微生物群落在环境中的分布特点及其对生态系统的影响,具有重要的研究意义和应用价值。
微生物群落在环境中的分布特点微生物在环境中广泛存在,其分布受到多种因素的影响,包括温度、PH值、湿度、氧气浓度、营养基质等。
根据其生长条件的不同,微生物分为嗜热菌、嗜酸菌、嗜碱菌、厌氧菌等不同类型。
同时,微生物也按其功能进行分类,如生物降解菌、氮循环菌等。
微生物群落在不同环境中的分布差异较大。
例如,在土壤中,常见的微生物有放线菌、链霉菌、芽孢杆菌等,它们能够分解降解有机物质、矿物质转化为植物营养物质。
而在水体中,微生物群落以浮游菌、底栖菌等为主,它们参与了水体的污染处理、养分循环等过程。
此外,微生物在生态系统中的分布也受到其它环境因素的影响,如生物和非生物因素的交互作用、人类活动等。
微生物群落对生态系统的影响微生物群落对生态系统具有至关重要的影响。
它们通过参与养分循环、生物降解和能量流动等过程,维持着生态系统的平衡。
例如,固氮菌能够转化空气中的氮气为植物可吸收的氨气,为植被生长提供了氮源。
同时,硝化细菌和反硝化细菌参与氮的循环,保障了生态系统的氮循环平衡。
微生物群落还参与生态系统的分解和降解作用,将有机物分解成无机物,使其能够再次回归到自然界中,形成新的有机物。
微生物还参与了废水和废气的净化作用,使大量有害物质减少或消失。
微生物群落还与宿主产生共生交互作用,如肠道菌群对人体健康的影响。
肠道菌群是人体内细菌群落,可促进食物的消化吸收,帮助代谢有益营养物质,增强机体的免疫功能。
多年的研究表明,肠道菌群与人体胃肠道的疾病有密切关系。
结语微生物群落的研究与应用在不断发展,在环保、农业、医学、生态学等领域得到了广泛的应用。
微生物群落的分布和特征具有多样性,不仅包括其遗传、形态的多样性,还存在着功能多样性。

大气中微生物的种类与分布特征分析引言:近年来,随着生态学的发展,对大气中微生物的研究日益受到人们的关注。
大气中的微生物数量巨大且多样,它们对气候变化、空气质量和人类健康具有重要影响。
本文将分析大气中微生物的种类和分布特征,探讨其在生态系统中的作用。
一、大气中微生物的种类大气中的微生物包括细菌、真菌、病毒等多种类型。
其中,细菌是大气中最常见的微生物群体。
常见的大气细菌主要有悬浮细菌和沉降细菌两类。
悬浮细菌主要存在于大气中的颗粒物表面,而沉降细菌则随着降雨等气候条件而沉降至地面。
真菌是大气中另一个重要的微生物类群。
它们通过产生孢子进行传播,能够在空气中长时间存在。
大气真菌主要包括霉菌、酵母菌等,它们在降雨过程中也可以通过沉降到地面。
此外,病毒也是大气微生物的一部分。
病毒可以通过空气传播,对人类和动物的健康构成一定威胁。
大气中常见的病毒有流感病毒、腺病毒等。
二、大气微生物的分布特征大气微生物的分布特征受多种因素影响。
首先是环境因素。
温度、湿度、光照等环境因素对大气微生物的生存和分布起着重要作用。
例如,高温高湿的环境有利于霉菌生长,而较低温度对某些细菌的生长有抑制作用。
其次是季节变化。
不同季节的气象条件和植被状况对大气微生物的分布有显著影响。
在春夏季节,细菌的数量往往较高,而在冬季则相对较低。
人类活动也对大气微生物的分布产生影响。
例如,工业废气和汽车尾气中的化学物质对大气中微生物的生存和分布具有一定的影响。
此外,农业活动和生活污水排放也可能导致大气微生物的富集。
三、大气微生物在生态系统中的作用大气微生物在生态系统中具有重要的功能和作用。
它们能够参与气候变化和物质循环过程。
首先,大气微生物通过氧化和还原反应参与大气中的气体转化。
例如,一些细菌能够氧化大气中的甲烷,减少其温室效应。
同时,微生物也能够参与有机物的分解,促进原始有机物的转化和再利用。
其次,大气微生物对空气质量具有重要影响。
一些微生物能够降解空气中的有机污染物,减轻空气污染的程度。

环境微生物学环境微生物学是研究微生物与环境相互作用的科学,它涵盖了微生物在各种环境中的分布、功能和相互关系,以及它们对环境的影响。
微生物在地球上广泛存在,包括土壤、水体、大气中以及与人类和动物共生的环境中。
它们扮演着维持生态平衡和生物地球化学循环的关键角色。
一、环境中的微生物分布微生物栖息在各种环境中,它们可以适应不同的温度、酸碱度、湿度和营养条件。
例如,土壤中的微生物非常丰富,包括细菌、真菌和病毒等。
水体中的微生物也很多样化,包括藻类、细菌和浮游动物等。
此外,大气中也存在着微生物,它们以微粒或气溶胶的形式存在,对大气的物理化学过程具有重要影响。
二、微生物在环境中的功能微生物在环境中发挥着多种功能。
首先,它们参与着有机物的降解和循环。
许多微生物能够分解有机废弃物,将其转化为二氧化碳和水。
此外,微生物还能够参与氮、磷、硫等元素的循环,促进养分的再利用。
其次,微生物在土壤中有助于植物的生长。
它们通过与植物根系形成共生关系,提供营养物质和促进植物免疫系统的发展。
此外,微生物还能够抵抗有害的生物入侵,保护植物的健康。
最后,微生物在水体中也具有重要作用,能够抑制蓝藻的生长、分解有毒物质,并维持水质的稳定。
三、微生物与环境的相互关系微生物与环境之间存在着复杂的相互关系。
微生物通过分泌代谢产物、产生酶和生物胶等方式与环境进行交互。
它们能够促进环境中的生物多样性,影响土壤质地和水质的特性。
同时,环境条件也会影响微生物的分布和功能。
温度、酸碱度、湿度等因素都会对微生物的生长和代谢产生影响。
此外,人类活动也对环境微生物产生了重要的影响。
例如,工业废水的排放、农药的使用和大气污染都会改变微生物的分布和群落结构,对生态系统产生负面影响。
四、环境微生物学的应用环境微生物学的研究成果在许多领域都有着实际应用。
首先,它在环境监测和评估中起到了重要的作用。
通过研究微生物群落的结构和功能,可以评估环境质量,并提供相关的环境保护策略。

生态环境中微生物的分布与功能生态环境是生物生存和发展的物质基础,也是维护生态系统稳定性的重要保障。
微生物是生态环境中最基础也是最重要的生物群体之一,它们在生态系统中发挥着至关重要的作用。
本文将从微生物的分布和功能两个方面介绍生态环境中微生物的重要性。
一、微生物的分布微生物广泛存在于自然界中,地球上所有生命体系都离不开微生物。
不同生态环境下的微生物种类和数量各异,下面就几个主要生态环境中微生物的分布进行简要介绍:1、土壤微生物土壤是生态系统的重要组成部分,微生物是土壤中最基础也是最丰富的生物群体之一。
土壤中的微生物种类多达数千种以上,包括细菌、真菌、放线菌等。
其中,真菌和放线菌是土壤生态系统中的关键微生物,它们分泌酶类物质,参与碳循环和氮循环等生态过程,同时也是土壤中重要的分解物质的微生物。
2、水体微生物水体中的微生物种类相对较少,主要包括浮游生物和底栖生物。
浮游生物包括细菌、原生动物、浮游藻和浮游真菌等。
底栖生物包括鱼类、甲壳类、软体动物等,它们的分布范围从浅海到深海、从河流到湖泊,生活方式和习性各不相同。
3、肠道微生物肠道微生物主要分布于人体肠道内,种类众多、数量庞大,估计每个人体内约有1.5千克的微生物群体。
肠道微生物对人体健康和生活质量的影响极大,例如帮助消化和吸收食物,维持免疫系统的正常功能等。
二、微生物的功能微生物在生态环境中具有多种重要功能,下面简要介绍几种常见的功能。
1、分解有机质微生物能够分解大量有机物质,使这些物质被完全降解和重复利用,有效促进了生物碳氮磷等元素的循环和再生。
微生物通过分泌酶类物质,将有机物质降解为较简单的化合物,其中包括能被植物吸收利用的营养元素。
2、促进土壤肥力微生物能够将土壤中的植物养分固定,将无机化合物转换为有机化合物,从而对土壤健康和肥力的维持起到非常重要的作用。
此外,微生物还有调节土壤酸碱度、减少土壤侵蚀等功能。
3、控制生态安全微生物在生态环境中还具有控制生态安全的重要作用,如对防止病原体和有毒物质的危害,促进生态系统健康和平衡。
微生物在环境中的分布与演化微生物是地球上存在时间最久的生物之一,它们广泛存在于自然界的各个角落,包括空气、水、土壤、生物体内等。
本文将探讨微生物在环境中的分布和演化。
一、微生物在自然环境中的分布微生物存在于自然环境中的形式多种多样,可以是单细胞的细菌、放线菌等,也可以是多细胞的卵菌、真菌等。
它们在不同的环境中分布不一,比较典型的环境如下:1.水体中的微生物分布水是微生物生长和繁殖的重要场所,水中微生物的分布实际上是跟水体的营养和生态密切相关的。
例如,水中的浮游生物(浮游细菌、藻类、浮游动物等)对水体中的营养和氧气需要很高,它们往往在富含营养物质的水体中集中分布;而水体中的底栖生物(底栖细菌、底栖动物等)则对氧气的需要较少,它们主要分布在水体底部的水泥等底栖生物体上。
2.土壤中的微生物分布土壤中的微生物分布跟土壤的物化性质、化学性质和生物量密切相关。
例如,土壤的物理结构决定了微生物在土壤中运动和分布的方式,粘土含量高的土壤会严重限制微生物的运动和分布;而土壤的化学性质则影响微生物的生长和代谢,酸性土壤中的微生物活动往往较低。
3.空气中的微生物分布空气中的微生物是通过自由落体和悬浮在空气中的粉尘、气溶胶等物质传播的。
空气中的微生物主要包括细菌、真菌和病毒等,它们的数量和种类随季节、空气质量和人群密度等因素的变化而变化。
二、微生物在环境中的演化微生物在自然界中的分布和演化是相互联系的,微生物对环境的适应和应变决定了它们的分布和数量。
微生物在环境中的演化主要有以下几种情况:1.为了适应生存条件,微生物进化出了不同的代谢方式和生存策略。
例如,一些细菌在干旱或寒冷的环境下会形成耐受孢,待环境条件改善时再恢复生长和繁殖;一些真菌则能分解木质素等复杂有机物,利用产生的化学能量维持生命活动。
2.微生物在环境中的互惠共生和竞争关系也在演化过程中不断变化。
例如,一些细菌和植物能够形成共生关系,细菌通过植物根系吸取养分,帮助植物吸收氮气等原始元素;而一些细菌也会产生抗生素等物质,与其他微生物进行竞争。
微生物种类繁多。
它们在自然界的分布非常广泛,它们存在于土壤、水、空气、动植物体和人体中,一些极端环境中也有微生物生存。
一、大气圈中的微生物大气圈中含有微生物,但因为大气中缺乏必需的营养物质和水分,加上太阳光中的紫外线照射,致使大气圈不能成为微生物生长繁殖的良好场所。
大气圈中的微生物主要是随尘埃飘浮到空中去的,而且多数以孢子或其它休眠体形态存在。
凡含尘埃较多的空气,其中所含的微生物种类与数量亦较多。
一般在禽畜舍、公共场所、医院、厕所、宿舍、城市繁华街道和居室内的空气中,微生物含量较高,而在海洋、高山、森林地带、终年积雪的山脉或极地上空的空气中,微生物的含量就极少。
空气中的微生物与空气中的温度、湿度等因素密切相关。
南方梅雨季节,空气中湿度大,霉菌含量很高,衣服等日用品极易发霉,而到了秋冬季,空气中的霉菌含量很少。
微生物在大气中的种类和数量随地区不同而有很大差异,同尘埃的总量和性质也有密切关系。
有些微生物类群经常出现于大气中,如霉菌、酵母菌、芽胞杆菌。
城市上空还经常出现病原微生物。
它们的数量和种类随季节的更替和气候的变化而有不同,如降水可以将微生物从空气中移走。
气流是空气中微生物传播的主要因素,有些种类可以借气流跨过大洋,造成世界性的分布。
大气微生物是环境和卫生科学工作者的重要研究对象。
二、岩石圈中的微生物岩石圈是生物学上不活跃部位。
地壳的岩石分为火成岩、沉积岩和变质岩,火成岩内部没有微生物生活的条件。
在岩石的裂隙中和岩石同水分与空气相接触的表面则是少数微生物的生境,常有细菌、藻类、真菌、地衣生长,称为岩生(rock inhabiting)微生物。
它们之中有些种类产生有机酸和螯合物,可以溶解硅酸盐和其它矿物,获得养料。
有些叫内岩生的微生物(endoliths)可以生活在某些岩石碎片层之下,甚至在深达450m岩层中也有生活着的微生物(Amg等,1993)。
20世纪90年代有些研究者配合地质勘探进行地下微生物研究,发现岩层中有多种微生物生存。
海洋微生物的种类与分布规律海洋微生物是指存在于海洋中的微小生物,体积很小,只能在显微镜下观察到。
它们是海洋生态系统中非常重要的一部分,包括不同种类的细菌、浮游生物等。
海洋微生物具有广泛的分布规律,不同种类的海洋微生物在不同的海洋环境中生存繁衍,形成了独特的生态系统。
一、海洋微生物的种类海洋微生物种类繁多,主要包括细菌、病毒、原生动物、浮游植物、浮游动物等。
1、细菌细菌是海洋中最常见的微生物之一,数量非常庞大。
它们主要生活在海水、泥沙和岩石表面等处,对海洋的生物循环和生态系统起到了重要的作用。
细菌有很多种类,按照形状和颜色的不同可以分为球形细菌、杆状细菌、螺旋形细菌等等。
2、病毒病毒是一种非常微小的生物,是海洋微生物中最小的一个种类。
虽然病毒不属于自主繁殖的生物,但它们对海洋生物的生存和循环也有一定的影响。
病毒主要通过寄生在海洋生物的体内进行传播,引起一些疾病和病变。
3、原生动物原生动物是一类单细胞的生物,数量非常庞大。
它们主要生活在海洋浮游生物中,包括甲壳类、放射虫、纤毛虫等。
原生动物起到了重要的食物链作用,并且在保持海洋生态系统稳定和平衡中发挥了很大的作用。
4、浮游植物浮游植物是一类生活在海洋中的植物,通常是一些较小的单细胞植物,例如藻类等。
浮游植物是海洋食物链中的重要组成部分,它们能够进行光合作用,产生能量,并且为海洋浮游动物提供食物源。
5、浮游动物浮游动物主要包括浮游生物和浮游性幼虫。
它们通常是一些较小的海洋生物,体型很小,数量非常庞大。
浮游动物是海洋生态系统中食物链最底层的一环,它们对维持海洋生态系统的平衡和稳定起到了重要的作用。
二、海洋微生物的分布规律海洋微生物的分布规律主要受到海洋环境、气候变化、生态系统等因素的影响。
1、海洋环境海洋环境是影响海洋微生物分布的最主要因素。
约70%的地球表面都是海洋,海洋环境多样,包括沿岸、近海和深海等。
不同的海洋环境中存在着不同的物种和微生物群体,相互之间的作用关系也不同。